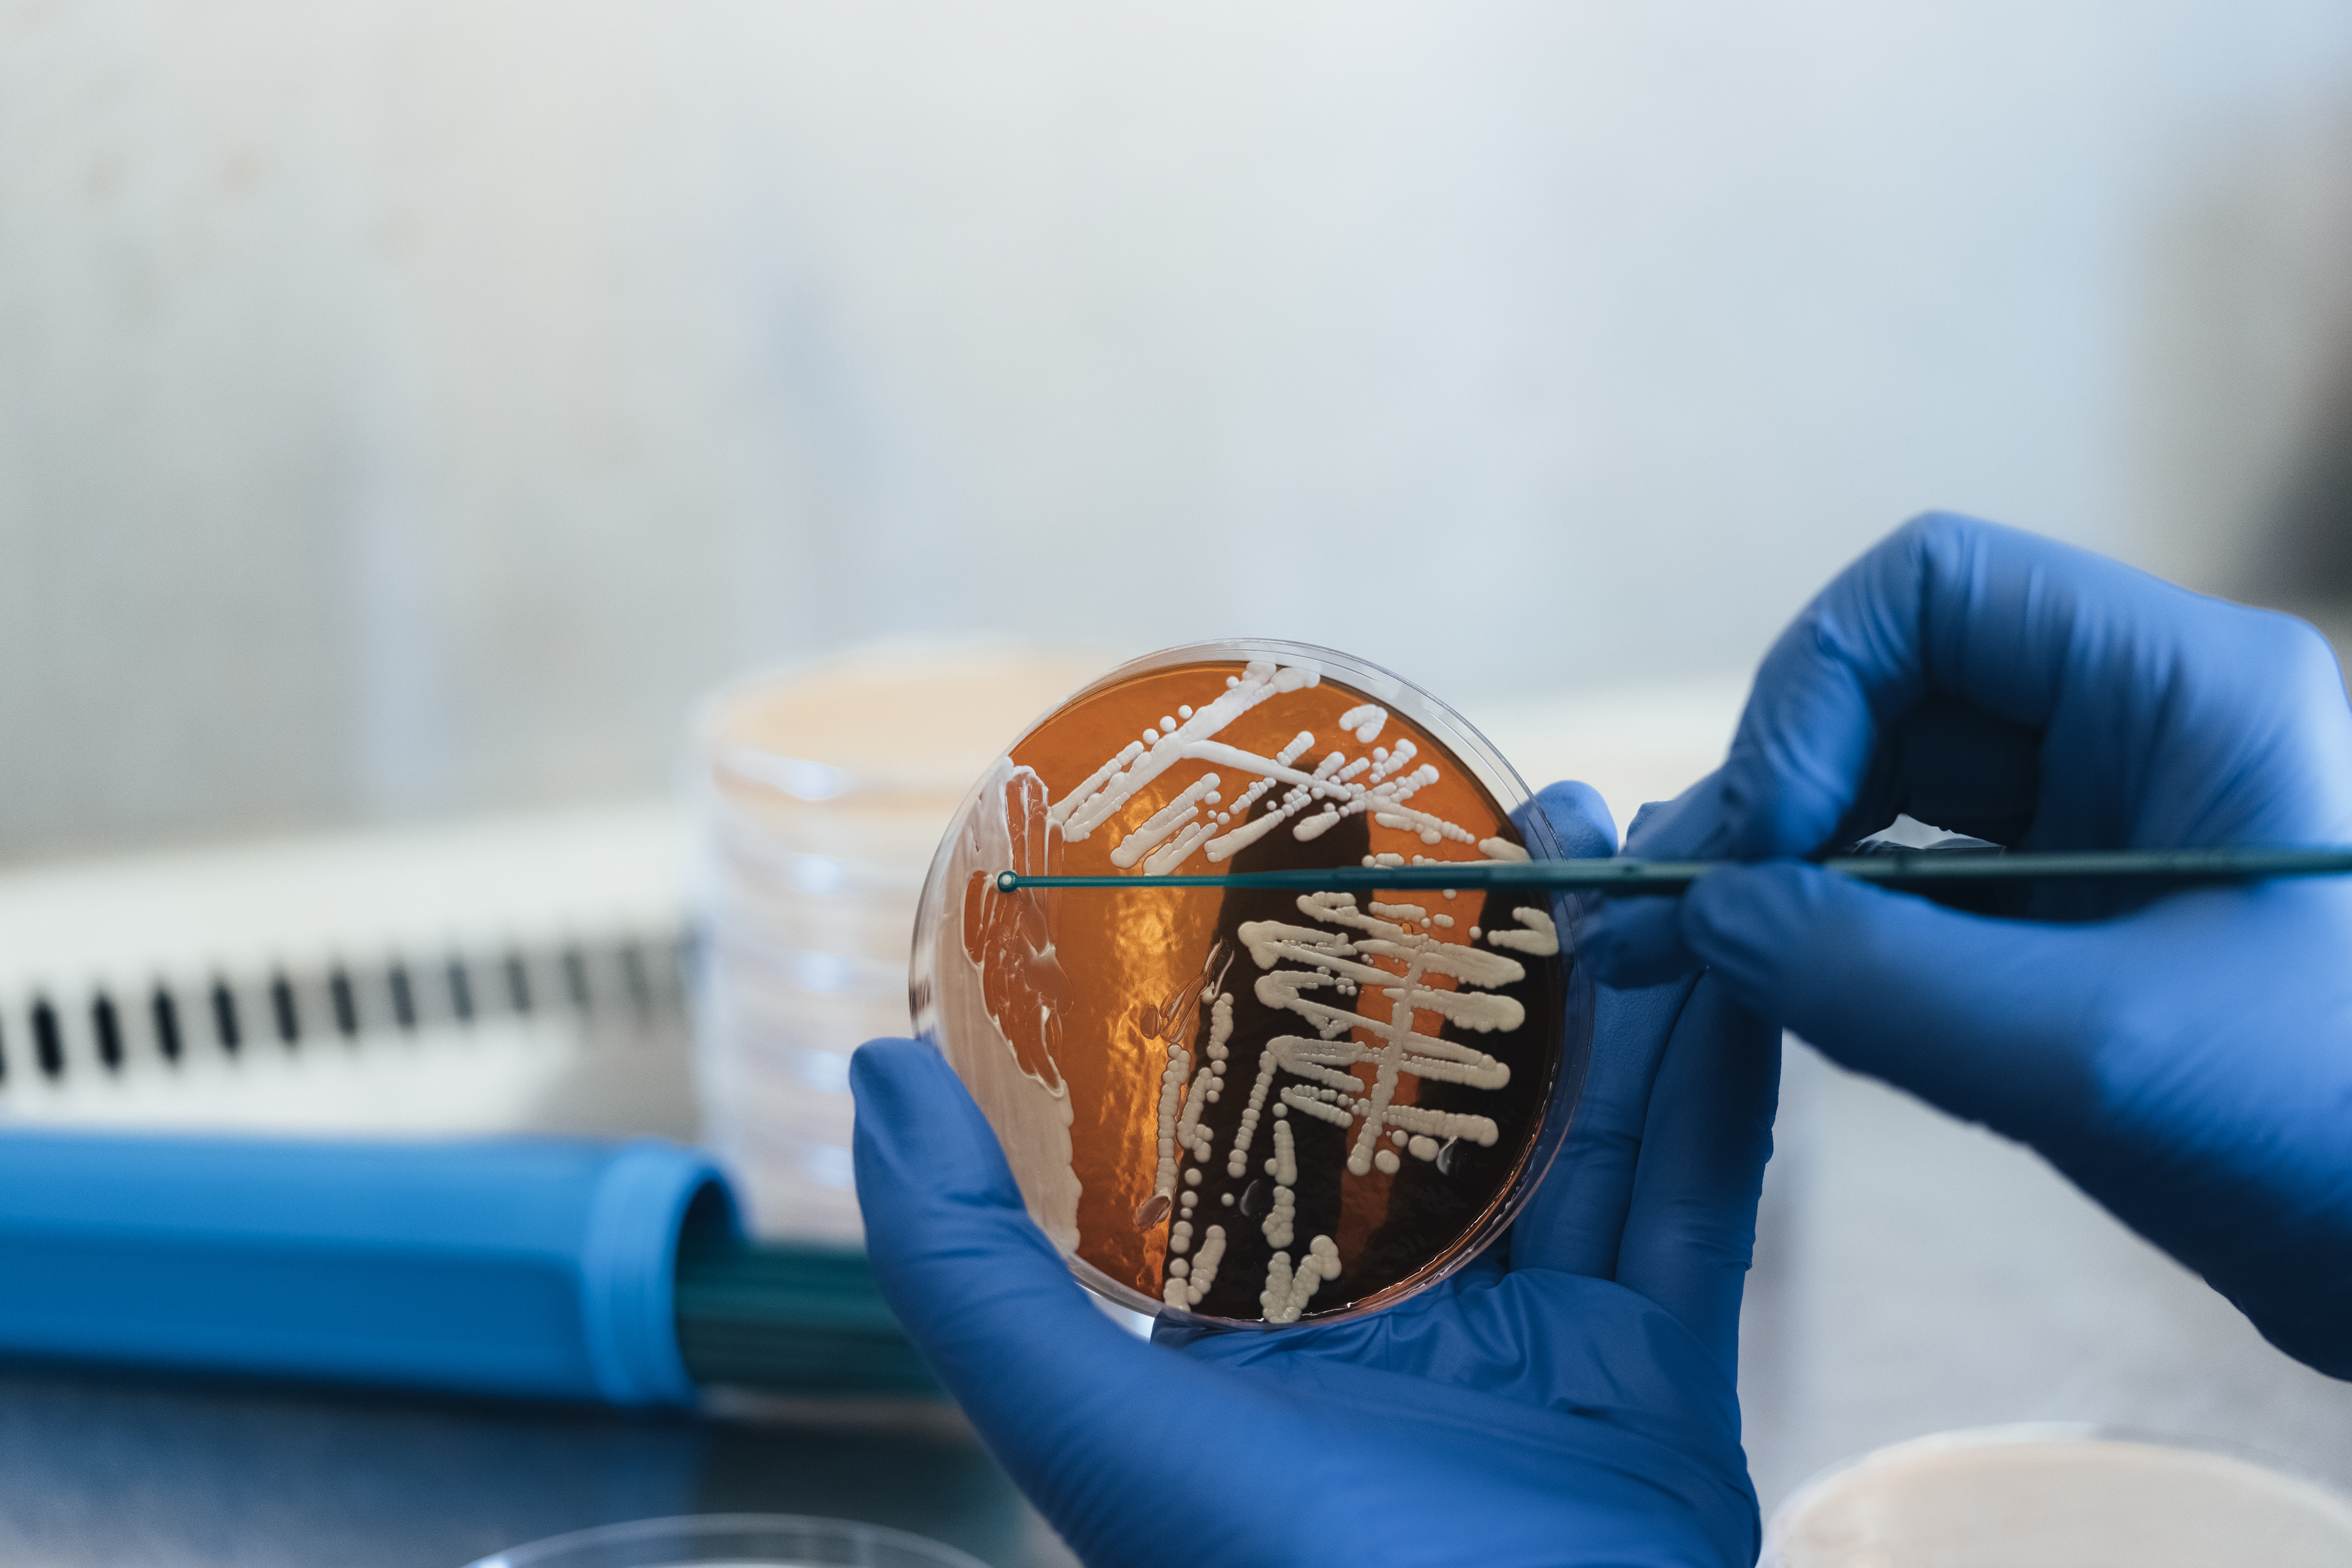

On assignment for Biosynth a film of the company's sites around Europe was created showcasing the strengths and cutting edge character of Biosynth. The film was then be displayed at the CPHI 2023, the biggest pharmaceutical fair in the world, in Barcelona.